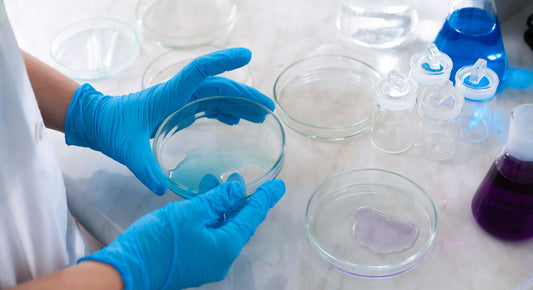

4LIFE US

4LIFE GLUCOACH PDF COMO SE TOMA
4Life Transfer Factor GluCoach. Respaldo específico para el equilibrio saludable de la glucosa* Haz clic en el siguiente enlace y DESCARGA GRATIS la ficha técnica de este Producto 4Life: 4LIFE GLUCOACH PDF...
4LIFE GLUCOACH PDF COMO SE TOMA
4Life Transfer Factor GluCoach. Respaldo específico para el equilibrio saludable de la glucosa* Haz clic en el siguiente enlace y DESCARGA GRATIS la ficha técnica de este Producto 4Life: 4LIFE GLUCOACH PDF...

4LIFE MALEPRO PDF COMO SE TOMA
4Life Transfer Factor MalePro. Palma enana americana, licopeno y hierbas para respaldar la salud de la próstata * Haz clic en el siguiente enlace y DESCARGA GRATIS la ficha técnica...
4LIFE MALEPRO PDF COMO SE TOMA
4Life Transfer Factor MalePro. Palma enana americana, licopeno y hierbas para respaldar la salud de la próstata * Haz clic en el siguiente enlace y DESCARGA GRATIS la ficha técnica...

4LIFE PLUS PDF COMO SE TOMA
4Life Transfer Factor Plus Tri-Factor Formula. El producto principal para el sistema inmunitario* Haz clic en el siguiente enlace y DESCARGA GRATIS la ficha técnica de este Producto 4Life: 4LIFE PLUS...
4LIFE PLUS PDF COMO SE TOMA
4Life Transfer Factor Plus Tri-Factor Formula. El producto principal para el sistema inmunitario* Haz clic en el siguiente enlace y DESCARGA GRATIS la ficha técnica de este Producto 4Life: 4LIFE PLUS...

4LIFE RIOVIDA PDF COMO SE TOMA
4Life Transfer Factor RioVida Tri-Factor Formula. El suplemento dietético líquido de mayor venta que contiene 4Life Transfer Factor y antioxidantes * Haz clic en el siguiente enlace y DESCARGA GRATIS...
4LIFE RIOVIDA PDF COMO SE TOMA
4Life Transfer Factor RioVida Tri-Factor Formula. El suplemento dietético líquido de mayor venta que contiene 4Life Transfer Factor y antioxidantes * Haz clic en el siguiente enlace y DESCARGA GRATIS...

4LIFE RIOVIDA TRANSFER FACTOR
El 4Life Transfer Factor Riovida es un producto de 4Life Research que contribuye al bienestar general con un enfoque en el apoyo al sistema inmunitario, y la salud celular (antioxidantes). A continuación,...
4LIFE RIOVIDA TRANSFER FACTOR
El 4Life Transfer Factor Riovida es un producto de 4Life Research que contribuye al bienestar general con un enfoque en el apoyo al sistema inmunitario, y la salud celular (antioxidantes). A continuación,...
4LIFE PLUS TRANSFER FACTOR
El 4Life Transfer Factor Plus es un producto de 4Life Research enfocadoen el refuerzo del sistema inmunitario que contiene una mezcla patentada de ingredientes clave, conocidos como "transfer factors", “factores de transferencia”...
4LIFE PLUS TRANSFER FACTOR
El 4Life Transfer Factor Plus es un producto de 4Life Research enfocadoen el refuerzo del sistema inmunitario que contiene una mezcla patentada de ingredientes clave, conocidos como "transfer factors", “factores de transferencia”...